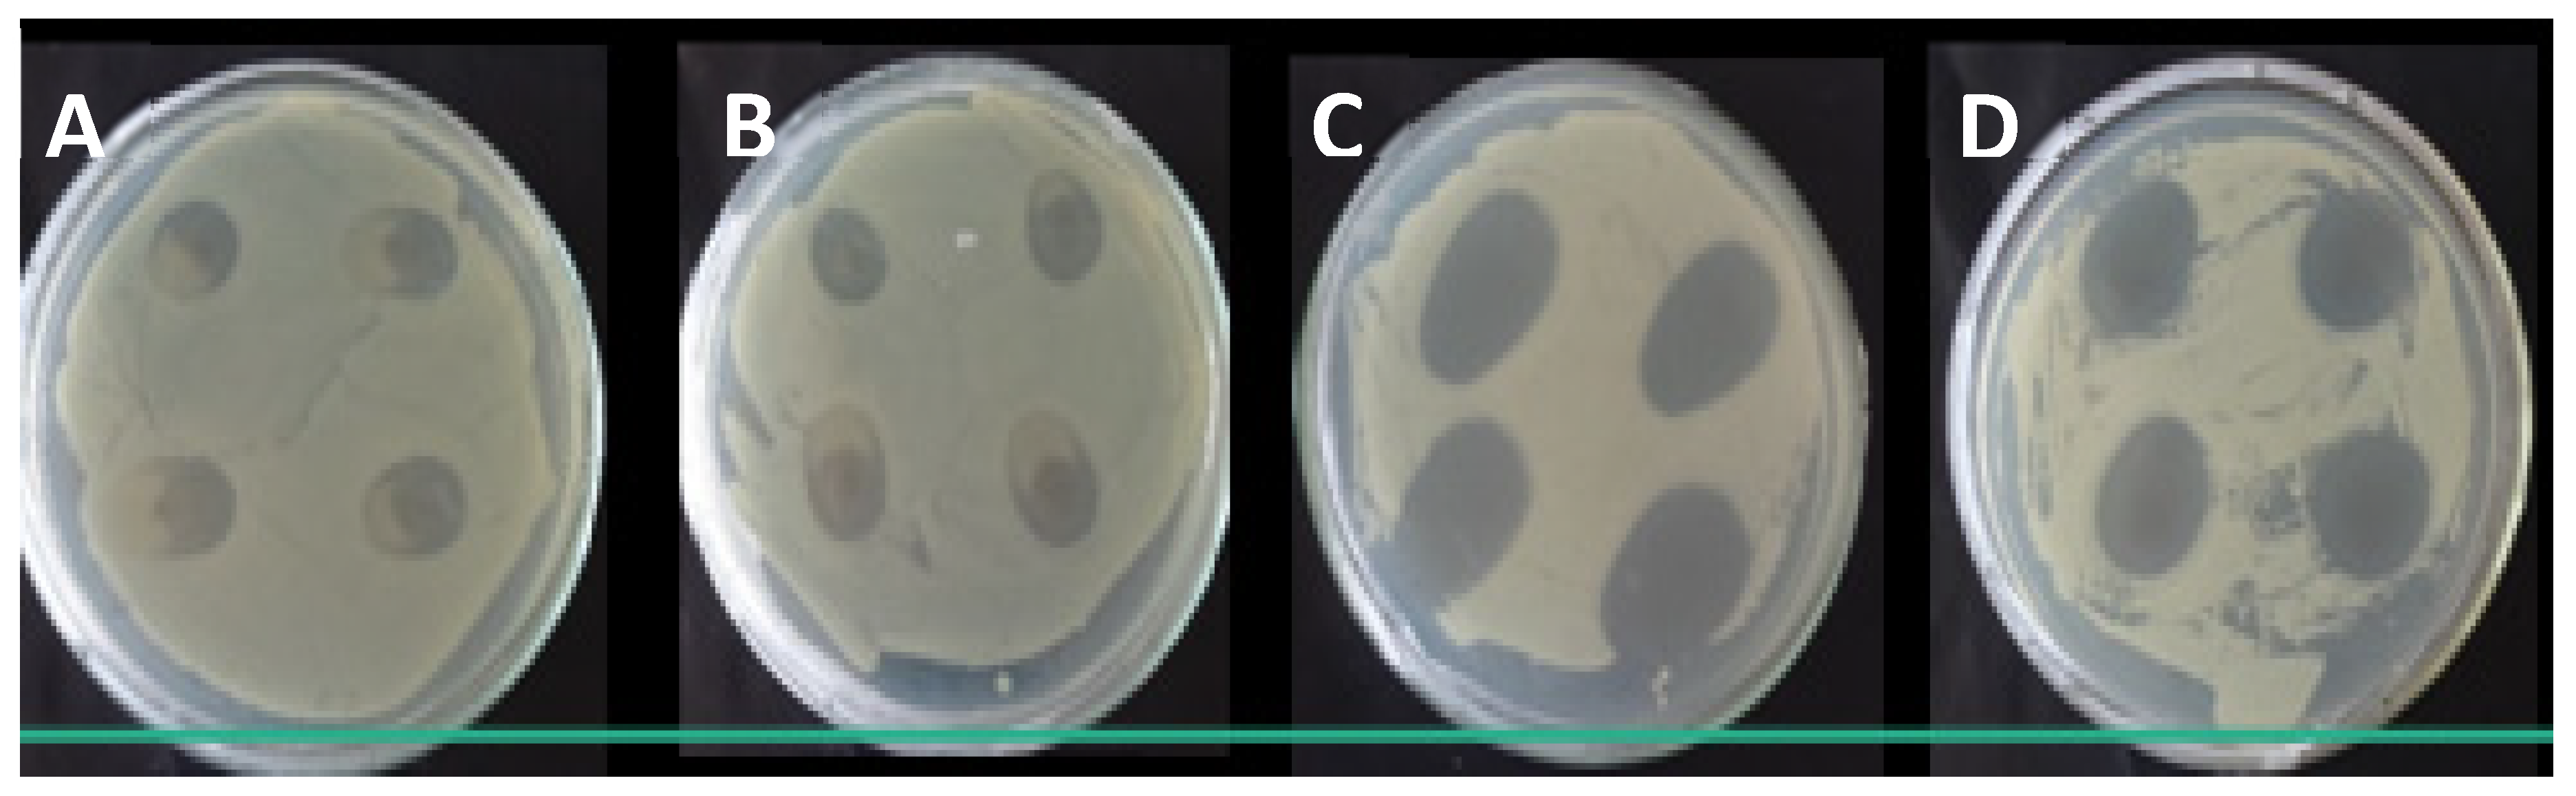
Polymers 13 04298 g006

Performance of Gelatin Films Reinforced with Cloisite Na+ and Black Pepper Essential Oil Loaded Nanoemulsion
Abstract
:1. Introduction
2. Materials and Methods
2.1. Materials
2.2. Nanoemulsion Preparation
2.3. Clay Dispersion Preparation
2.4. Film Preparation
2.5. Film Characterization
2.5.1. Scanning Electron Microscopy (SEM)
2.5.2. Water Vapor Permeability (WVP)
2.5.3. Mechanical Properties
2.5.4. Contact Angle
2.5.5. Thermogravimetric Analysis (TG)
2.5.6. X-ray Diffraction (XRD)
2.5.7. Microbiological Analysis
2.5.8. Statistical Analysis
3. Results and Discussion
3.1. Nanoemulsion Mean Particle Size
3.2. Clay Dispersion Mean Particle Size and Zeta Potential
3.3. Scanning Electron Microscopy (SEM)
3.4. Water Vapor Permeabilty (WVP)
3.5. Mechanical Properties
3.6. Contact Angle
3.7. Thermogravimetric Analysis (TG)
3.8. X-Ray Diffraction (XDR)
3.9. Microbiological Analysis
4. Conclusions
Author Contributions
Funding
Institutional Review Board Statement
Informed Consent Statement
Acknowledgments
Conflicts of Interest
References
- Bendahou, D.; Bendahou, A.; Grohens, Y.; Kaddami, H. New nanocomposite design from zeolite and poly(lactic acid). Ind. Crops Prod. 2015, 72, 107–118. [Google Scholar] [CrossRef]
- Souza, V.G.L.; Fernando, A.L. Nanoparticles in food packaging: Biodegradability and potential migration to food—A review. Food Packag. Shelf Life 2016, 8, 63–70. [Google Scholar] [CrossRef]
- Garavand, F.; Cacciotti, I.; Vahedikia, N.; Rehman, A.; Tarhan, Ö.; Akbari-Alavijeh, S.; Shaddel, R.; Rashidinejad, A.; Nejatian, M.; Jafarzadeh, S.; et al. A comprehensive review on the nanocomposites loaded with chitosan nanoparticles for food packaging. Crit. Rev. Food Sci. Nutr. 2020, 1–34. [Google Scholar] [CrossRef]
- Qin, M.; Chen, C.; Song, B.; Shen, M.; Cao, W.; Yang, H.; Zeng, G.; Gong, J. A review of biodegradable plastics to biodegradable microplastics: Another ecological threat to soil environments? J. Clean. Prod. 2021, 312, 127816. [Google Scholar] [CrossRef]
- Souza, V.G.L.; Pires, J.R.; Rodrigues, P.F.; Lopes, A.A.; Fernandes, F.M.; Duarte, M.P.; Fernando, A.L. Bionanocomposites of chitosan/montmorillonite incorporated with Rosmarinus officinalis essential oil: Development and physical characterization. Food Packag. Shelf Life 2018, 16, 148–156. [Google Scholar] [CrossRef]
- Lee, J.H.; Lee, J.; Song, K.B. Development of a chicken feet protein film containing essential oils. Food Hydrocoll. 2015, 46, 208–215. [Google Scholar] [CrossRef]
- Shaaban, H.A.; Mahmoud, K.F.; Ibrahim, M.A.; Ibrahim, G. Antimicrobial activity of edible methyl cellulose films enriched with essential oils against three common foodborne pathogens. World Appl. Sci. J. 2014, 32, 2092–2101. [Google Scholar]
- Yahyaoui, M.; Gordobil, O.; Díaz, R.H.; Abderrabba, M.; Labidi, J. Development of novel antimicrobial films based on poly(lactic acid) and essential oils. React. Funct. Polym. 2016, 109, 1–8. [Google Scholar] [CrossRef]
- Cozmuta, A.M.; Turila, A.; Apjok, R.; Ciocian, A.; Cozmuta, L.M.; Peter, A.; Nicula, C.; Galić, N.; Benković, T. Preparation and characterization of improved gelatin films incorporating hemp and sage oils. Food Hydrocoll. 2015, 49, 144–155. [Google Scholar] [CrossRef]
- Rhim, J.-W.; Park, H.-M.; Ha, C.-S. Bio-nanocomposites for food packaging applications. Prog. Polym. Sci. 2013, 38, 1629–1652. [Google Scholar] [CrossRef]
- Cacciotti, I.; Mori, S.; Cherubini, V.; Nanni, F. Eco-sustainable systems based on poly(lactic acid), diatomite and coffee grounds extract for food packaging. Int. J. Biol. Macromol. 2018, 112, 567–575. [Google Scholar] [CrossRef] [Green Version]
- Beverlya, R.L.; Janes, M.E.; Prinyawiwatkula, W.; No, H.K. Edible chitosan films on ready-to-eat roast beef for the control of Listeria monocytogenes. Food Microbiol. 2008, 25, 534–537. [Google Scholar] [CrossRef] [PubMed]
- Krepker, M.; Shemesh, R.; Poleg, Y.D.; Kashi, Y.; Vaxman, A.; Segal, E. Active food packaging films with synergistic antimicrobial activity. Food Control 2017, 76, 117–126. [Google Scholar] [CrossRef]
- Kujumgiev, A.; Tsvetkova, I.; Serkedjieva, Y.; Bankova, V.; Christov, R.; Popov, S. Antibacterial, antifungal and antiviral activity of propolis of different geographic origin. J. Ethnopharmacol. 1999, 64, 235–240. [Google Scholar] [CrossRef]
- Muriel-Galet, V.; Cran, M.J.; Bigger, S.W.; Hernández-Muñoz, P.; Gavara, R. Antioxidant and antimicrobial properties of ethylene vinyl alcohol copolymer films based on the release of oregano essential oil and green tea extract components. J. Food Eng. 2015, 149, 9–16. [Google Scholar] [CrossRef]
- Gherardi, R.; Becerril, R.; Nerin, C.; Bosetti, O. Development of a multilayer antimicrobial packaging material for tomato puree using an innovative technology. LWT 2016, 72, 361–367. [Google Scholar] [CrossRef]
- Solaberrieta, I.; Jiménez, A.; Cacciotti, I.; Garrigós, M.C. Encapsulation of Bioactive Compounds from Aloe Vera Agrowastes in Electrospun Poly (Ethylene Oxide) Nanofibers. Polymers 2020, 12, 1323. [Google Scholar] [CrossRef] [PubMed]
- Jovanović, J.; Ćirković, J.; Radojković, A.; Mutavdžić, D.; Tanasijević, G.; Joksimović, K.; Bakić, G.; Branković, G.; Branković, Z. Chitosan and pectin-based films and coatings with active components for application in antimicrobial food packaging. Prog. Org. Coat. 2021, 158, 106349. [Google Scholar] [CrossRef]
- Burt, S. Essential oils: Their antibacterial properties and potential applications in foods—A review. Int. J. Food Microbiol. 2004, 94, 223–253. [Google Scholar] [CrossRef]
- Kale, G.; Kijchavengkul, T.; Auras, R.; Rubino, M.; Selke, S.E.; Singh, S.P. Compostability of Bioplastic Packaging Materials: An Overview. Macromol. Biosci. 2007, 7, 255–277. [Google Scholar] [CrossRef]
- Nitsuwat, S.; Zhang, P.; Ng, K.; Fang, Z. Fish gelatin as an alternative to mammalian gelatin for food industry: A meta-analysis. LWT 2021, 141, 110899. [Google Scholar] [CrossRef]
- Cetinkaya, T.; Altay, F.; Ceylan, Z. A new application with characterized oil-in-water-in-oil double emulsions: Gelatin-xanthan gum complexes for the edible oil industry. LWT 2021, 138, 110773. [Google Scholar] [CrossRef]
- Rao, Y. Gelatin-clay nanocomposites of improved properties. Polymer 2007, 48, 5369–5375. [Google Scholar] [CrossRef]
- Suderman, N.; Isa, M.I.N.M.; Sarbon, N.M. The effect of plasticizers on the functional properties of biodegradable gelatin-based film: A review. Food Biosci. 2018, 24, 111–119. [Google Scholar] [CrossRef]
- Alexandre, E.; Lourenço, R.V.; Bittante, A.M.Q.B.; Moraes, I.; Sobral, P.J.D.A. Gelatin-based films reinforced with montmorillonite and activated with nanoemulsion of ginger essential oil for food packaging applications. Food Packag. Shelf Life 2016, 10, 87–96. [Google Scholar] [CrossRef]
- Ray, S.S.; Okamoto, M. Polymer/layered silicate nanocomposites: A review from preparation to processing. Prog. Polym. Sci. 2003, 28, 1539–1641. [Google Scholar] [CrossRef]
- Sousa, A.I.; Ferreira, I.M.; Faria, M.A. Sensitive detection of Piper nigrum L. adulterants by a novel screening approach based on qPCR. Food Chem. 2019, 283, 596–603. [Google Scholar] [CrossRef]
- Nisha, P.; Singhal, R.S.; Pandit, A.B. The degradation kinetics of flavor in black pepper (Piper nigrum L.). J. Food Eng. 2009, 92, 44–49. [Google Scholar] [CrossRef]
- Espitia, P.J.P.; Avena-Bustillos, R.J.; Du, W.X.; Teófilo, R.F.; Soares, N.F.; McHugh, T.H. Optimal antimicrobial formulation and physical-mechanical properties of edible films based on açaí and pectin for food preservation. Food Packag. Shelf Life 2014, 2, 38–49. [Google Scholar] [CrossRef]
- American Society for Testing and Materials. Standard Test Method for Tensile Properties of Thin Plastic Sheeting D882-97. Annual Book of ASTM Standards; American Society for Testing and Materials: West Conshohocken, PA, USA, 1996. [Google Scholar]
- Clinical and Laboratory Standards Institute (CLSI). Performance Standards for Antimicrobial Disk Susceptibility Tests, 11th ed.; Approved Standard; CLSI Document M02-A11; Clinical and Laboratory Standards Institute: Wayne, PA, USA, 2012. [Google Scholar]
- Fernandez, P.; André, V.; Rieger, J.; Kühnle, A. Nano-emulsion formation by emulsion phase inversion. Colloids Surf. A Physicochem. Eng. Asp. 2004, 251, 53–58. [Google Scholar] [CrossRef] [Green Version]
- Lorevice, M.V.; Otoni, C.; de Moura, M.R.; Mattoso, L.H.C. Chitosan nanoparticles on the improvement of thermal, barrier, and mechanical properties of high- and low-methyl pectin films. Food Hydrocoll. 2016, 52, 732–740. [Google Scholar] [CrossRef] [Green Version]
- Calvo, P.; Remunan-Lopez, C.; Vila-Jato, J.L.; Alonso, M.J. Novel hydrophilic chitosan-polyethylene oxide nanoparticles as protein carriers. J. Appl. Polym. Sci. 1997, 63, 125–132. [Google Scholar] [CrossRef]
- Benita, S.; Levy, M. Submicron Emulsions as Colloidal Drug Carriers for Intravenous Administration: Comprehensive Physicochemical Characterization. J. Pharm. Sci. 1993, 82, 1069–1079. [Google Scholar] [CrossRef]
- Melo, P.T.S.; Aouada, F.A.; Moura, M.R.D. Fabricação de filmes bionanocompósitos à base de pectina e polpa de cacau com potencial uso como embalagem para alimentos. Quím. Nova 2017, 40, 247–251. [Google Scholar] [CrossRef]
- Chen, P.; Zhang, L. Interaction and Properties of Highly Exfoliated Soy Protein/Montmorillonite Nanocomposites. Biomacromolecules 2006, 7, 1700–1706. [Google Scholar] [CrossRef]
- Flaker, C.H.C.; Lourenço, R.V.; Bittante, A.M.; Sobral, P.J. Gelatin-based nanocomposite films: A study on montmorillonite dispersion methods and concentration. J. Food Eng. 2015, 167, 65–70. [Google Scholar] [CrossRef]
- Atarés, L.; Bonilla, J.; Chiralt, A. Characterization of sodium caseinate-based edible films incorporated with cinnamon or ginger essential oils. J. Food Eng. 2010, 100, 678–687. [Google Scholar] [CrossRef]
- Bonilla, J.; Poloni, T.; Lourenço, R.V.; Sobral, P.J. Antioxidant potential of eugenol and ginger essential oils with gelatin/chitosan films. Food Biosci. 2018, 23, 107–114. [Google Scholar] [CrossRef]
- Córdoba, L.J.P.; Sobral, P.J. Physical and antioxidant properties of films based on gelatin, gelatin-chitosan or gelatin-sodium caseinate blends loaded with nanoemulsified active compounds. J. Food Eng. 2017, 213, 47–53. [Google Scholar] [CrossRef]
- Cacciotti, I.; Lombardelli, C.; Benucci, I.; Esti, M. Clay/chitosan biocomposite systems as novel green carriers for covalent immobilization of food enzymes. J. Mater. Res. Technol. 2019, 8, 3644–3652. [Google Scholar] [CrossRef]
- Bergo, P.; Sobral, P. Effects of plasticizer on physical properties of pigskin gelatin films. Food Hydrocoll. 2007, 21, 1285–1289. [Google Scholar] [CrossRef]
- Ji, M.; Wu, J.; Sun, X.; Guo, X.; Zhu, W.; Li, Q.; Shi, X.; Tian, Y.; Wang, S. Physical properties and bioactivities of fish gelatin films incorporated with cinnamaldehyde-loaded nanoemulsions and vitamin C. LWT 2021, 135, 110103. [Google Scholar] [CrossRef]
- Altiok, D.; Altiok, E.; Tihminlioglu, F. Physical, antibacterial and antioxidant properties of chitosan films incorporated with thyme oil for potential wound healing applications. J. Mater. Sci. Mater. Med. 2010, 21, 2227–2236. [Google Scholar] [CrossRef] [PubMed] [Green Version]
- Kavoosi, G.; Rahmatollahi, A.; Dadfar, S.M.M.; Purfard, A.M. Effects of essential oil on the water binding capacity, physico-mechanical properties, antioxidant and antibacterial activity of gelatin films. LWT 2014, 57, 556–561. [Google Scholar] [CrossRef]
- Nunes, J.C.; Melo, P.T.S.; Aouada, F.A.; Moura, M.R.D. Influência da nanoemulsão de óleo essencial de limão em filmes à base de gelatina. Quím. Nova 2018, 41, 1006–1010. [Google Scholar] [CrossRef]
- De Moura, M.R.; Aouada, F.A.; Avena-Bustillos, R.J.; McHugh, T.H.; Krochta, J.M.; Mattoso, L.H.C. Improved barrier and mechanical properties of novel hydroxypropyl methylcellulose edible films with chitosan/tripolyphosphate nanoparticles. J. Food Eng. 2009, 92, 448–453. [Google Scholar] [CrossRef]
- Cao, T.L.; Song, K.B. Active gum karaya/Cloisite Na+ nanocomposite films containing cinnamaldehyde. Food Hydrocoll. 2019, 89, 453–460. [Google Scholar] [CrossRef]
- Mendes, J.F.; Norcino, L.B.; Martins, H.H.A.; Manrich, A.; Otoni, C.G.; Carvalho, E.E.N.; Piccoli, R.H.; Oliveira, J.E.; Pinheiro, A.C.M.; Mattoso, L.H.C. Correlating emulsion characteristics with the properties of active starch films loaded with lemongrass essential oil. Food Hydrocoll. 2020, 100, 105428. [Google Scholar] [CrossRef]
- Zolfi, M.; Khodaiyan, F.; Mousavi, M.; Hashemi, M. The improvement of characteristics of biodegradable films made from kefiran–whey protein by nanoparticle incorporation. Carbohydr. Polym. 2014, 109, 118–125. [Google Scholar] [CrossRef]
- Benucci, I.; Liburdi, K.; Cacciotti, I.; Lombardelli, C.; Zappino, M.; Nanni, F.; Esti, M. Chitosan/clay nanocomposite films as supports for enzyme immobilization: An innovative green approach for winemaking applications. Food Hydrocoll. 2018, 74, 124–131. [Google Scholar] [CrossRef]
- Benucci, I.; Lombardelli, C.; Cacciotti, I.; Esti, M. Papain Covalently Immobilized on Chitosan–Clay Nanocomposite Films: Application in Synthetic and Real White Wine. Nanomaterials 2020, 10, 1622. [Google Scholar] [CrossRef]
- Vahedikia, N.; Garavand, F.; Tajeddin, B.; Cacciotti, I.; Jafari, S.M.; Omidi, T.; Zahedi, Z. Biodegradable zein film composites reinforced with chitosan nanoparticles and cinnamon essential oil: Physical, mechanical, structural and antimicrobial attributes. Colloids Surf. B Biointerfaces 2019, 177, 25–32. [Google Scholar] [CrossRef] [PubMed]
- Otoni, C.G.; de Moura, M.R.; Aouada, M.R.D.M.; Camilloto, G.P.; Cruz, R.S.; Lorevice, M.V.; Soares, N.D.F.; Mattoso, L.H. Antimicrobial and physical-mechanical properties of pectin/papaya puree/cinnamaldehyde nanoemulsion edible composite films. Food Hydrocoll. 2014, 41, 188–194. [Google Scholar] [CrossRef]
- Acevedo-Fani, A.; Salvia-Trujillo, L.; Rojas-Graü, M.A.; Martín-Belloso, O. Edible films from essential-oil-loaded nanoemulsions: Physicochemical characterization and antimicrobial properties. Food Hydrocoll. 2015, 47, 168–177. [Google Scholar] [CrossRef] [Green Version]
- Roy, S.; Rhim, J.W. Gelatin/agar-based functional film integrated with Pickering emulsion of clove essential oil stabilized with nanocellulose for active packaging applications. Colloids Surf. A Physicochem. Eng. Asp. 2021, 627, 127220. [Google Scholar] [CrossRef]
- Martucci, J.F.; Vazquez, A.; Ruseckaite, R.A. Nanocomposites based on gelatin and montmorillonite. J. Therm. Anal. Calorim. 2007, 89, 117–122. [Google Scholar] [CrossRef]
- Pereda, M.; Ponce, A.G.; Marcovich, N.E.; Ruseckaite, R.A.; Martucci, J.F. Chitosan-gelatin composites and bi-layer films with potential antimicrobial activity. Food Hydrocoll. 2011, 25, 1372–1381. [Google Scholar] [CrossRef]
- Ojagh, S.M.; Rezaei, M.; Razavi, S.H.; Hosseini, S.M.H. Development and evaluation of a novel biodegradable film made from chitosan and cinnamon essential oil with low affinity toward water. Food Chem. 2010, 122, 161–166. [Google Scholar] [CrossRef]
- Peng, Y.; Li, Y. Combined effects of two kinds of essential oils on physical, mechanical and structural properties of chitosan films. Food Hydrocoll. 2014, 36, 287–293. [Google Scholar] [CrossRef]

| Samples | Film Composition |
|---|---|
| GE | gelatin 5% |
| GEP1 | gelatin 5% + 50 mL nanonoemulsion P1 |
| GEP2 | gelatin 5% + 50 mL nanonoemulsion P2 |
| GEP3 | gelatin 5% + 50 mL nanonoemulsion P3 |
| GEP4 | gelatin 5% + 50 mL nanonoemulsion P4 |
| GEDA | gelatin 5% + 50 mL clay dispersion |
| GEP4DA | gelatin 5% + 50 mL nanonoemulsion P4 + 50 mL clay dispersion |
| Samples | Thickness (µm) | WVP (g mm/kPa h m2) | Tensile Strength | Elongation (%) |
|---|---|---|---|---|
| GE | 48 ± 1 b | 0.32 ± 0.02 c | 57.16 ± 3.54 e | 2.96 ± 0.39 c |
| GEP1 | 47 ± 5 b | 0.61 ± 0.09 a | 64.05 ± 2.61 d | 7.77 ± 0.91 a |
| GEP2 | 47 ± 4 b | 0.57 ± 0.06 a | 67.33 ± 2.06 cd | 6.83 ± 0.96 a |
| GEP3 | 47 ± 4 b | 0.52 ± 0.03 ab | 71.04 ± 2.75 bcd | 7.08 ± 0.81 a |
| GEP4 | 66 ± 5 a | 0.37 ± 0.05 c | 74.23 ± 1.96 bc | 5.03 ± 0.75 b |
| GEDA | 71 ± 7 a | 0.38± 0.03 bc | 150.72 ± 8.54 a | 2.78 ± 0.42 c |
| GEP4DA | 70 ± 7 a | 0.45 ± 0.04 abc | 77.32 ± 3.21 b | 1.82 ± 0.31 c |
| Samples | Contact Angle (°) |
|---|---|
| GE | 72 ± 1° b |
| GEP4 | 47 ± 7° d |
| GEDA | 79 ± 3° a |
| GEP4DA | 64 ± 5° c |
| Films | E. coli (mm2) | S. aureus (mm2) |
|---|---|---|
| GE | 0 | 0 |
| GEDA | 0 | 0 |
| GEP4 | 95.50 ± 0.53 a | 1.20 ± 0.10 c |
| GEP4DA | 49.35 ± 0.90 b | 0 |
Publisher’s Note: MDPI stays neutral with regard to jurisdictional claims in published maps and institutional affiliations. |
© 2021 by the authors. Licensee MDPI, Basel, Switzerland. This article is an open access article distributed under the terms and conditions of the Creative Commons Attribution (CC BY) license (https://creativecommons.org/licenses/by/4.0/).
Share and Cite
Saranti, T.F.d.S.; Melo, P.T.S.; Cerqueira, M.A.; Aouada, F.A.; de Moura, M.R. Performance of Gelatin Films Reinforced with Cloisite Na+ and Black Pepper Essential Oil Loaded Nanoemulsion. Polymers 2021, 13, 4298. https://doi.org/10.3390/polym13244298
Saranti TFdS, Melo PTS, Cerqueira MA, Aouada FA, de Moura MR. Performance of Gelatin Films Reinforced with Cloisite Na+ and Black Pepper Essential Oil Loaded Nanoemulsion. Polymers. 2021; 13(24):4298. https://doi.org/10.3390/polym13244298
Chicago/Turabian StyleSaranti, Tascila F. da S., Pamela T. S. Melo, Miguel A. Cerqueira, Fauze A. Aouada, and Marcia R. de Moura. 2021. "Performance of Gelatin Films Reinforced with Cloisite Na+ and Black Pepper Essential Oil Loaded Nanoemulsion" Polymers 13, no. 24: 4298. https://doi.org/10.3390/polym13244298
APA StyleSaranti, T. F. d. S., Melo, P. T. S., Cerqueira, M. A., Aouada, F. A., & de Moura, M. R. (2021). Performance of Gelatin Films Reinforced with Cloisite Na+ and Black Pepper Essential Oil Loaded Nanoemulsion. Polymers, 13(24), 4298. https://doi.org/10.3390/polym13244298

